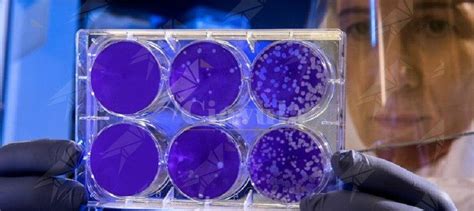

Scommetto 1 Milione di Dollari che il Virus è Ben Altro. Perché Tutti Hanno Paura di Puntare su di Me?
Steve Kirsch noto imprenditore seriale high tech ed investigatore in rete, ha creato dieci diverse offerte di scommesse da $ 1 milione per risolvere problemi importanti in cui c’è disaccordo. Le scommesse sono cose come:
- Esistono virus?
- SARS-CoV-2 è un virus reale o una sequenza generata dal computer che tutti copiano?
- SARS-CoV-2 è stato generato in laboratorio o in natura?
- …eccetera…

Abbiate l’accortezza di leggere tutti i punti della questione per avere un idea ben precisa su come viene posta la scommessa che tutti badate bene possono intraprendere.
A tutti coloro che si sono in questi tre anni sporcati la bocca dando enfasi al fatto che i No-Vax erano gli estremi untori del pianeta, è offerta loro un opportunità unica offerta su un piatto d’oro di guadagnare un milione di dollari, (E’ tutto vero!!!) dimostrando al mondo che avevano ragione e poter risolvere allo stesso tempo tutti i problemi della propria vita, dando un significato finalmente alle verità (?) che in tutti questi anni hanno portato avanti con tanto accanimento.
Leggete attentamente, ogni pratica è stata fatta seguendo ogni regola che si conviene quanto si stipulano dei contratti ufficiali.
Tutto quello che dovrete fare è dimostrare davanti ad una commissione scientifica imparziale secondo tutte le normative di legge ogni punto posto nel documento a cui poi si deve porre la propria firma per il consenso partecipativo.
I Si-Vax che non lo fanno o sono dei vigliacchi o dei cialtroni, o sono gente che non ha bisogno di un milione di dollari…..
A tutti i meschini politici e televisivi mediatici come Roberto Brindisi, Matteo Bassetti, Roberto Brunetta, Fabrizio Pregliasco, Roberto Burioni, Luca Zaia, Roberto Speranza (Avete notato quanti Roberto ci sono?) e i loro spudorati seguaci, è offerta loro l’opportunità di dare seguito alle parole pure i fatti, che a quanto pare nemmeno qualche milione di morti pare averli intaccati, ma ora per dare un senso ed un significato a tutti questi cadaveri possono finalmente guadagnare, lo ripetiamo, un milione di dollari!!
Solo degli esseri umani spregevoli possono sottrarsi a questa opportunità che noi della redazione di toba60 offriamo loro sul palmo della mano.
…… fermo restando che degli idioti non hanno proprio bisogno di guadagnare tanto.
ahh …dimenticavo, la lista di chi si candida alla scommessa viene aggiornata in tempo reale su questo indirizzo, fatevi avanti su….. e poi andate a farvi una bella iniezione di fiducia in ospedale che ne avete veramente bisogno.
Toba60
Il nostro lavoro come ai tempi dell’inquisizione è diventato attualmente assai difficile e pericoloso, ci sosteniamo in prevalenza grazie alle vostre donazioni volontarie mensili e possiamo proseguire solo grazie a queste, contribuire è facile, basta inserire le vostre coordinate già preimpostate all’interno dei moduli all’interno degli editoriali e digitare un importo sulla base della vostra disponibilità.Se apprezzate quello che facciamo, fate in modo che possiamo continuare a farlo sostenendoci oggi stesso…
Non delegate ad altri quello che potete fare anche voi.
Staff Toba60
Meno dello 0,1% dei nostri lettori ci supporta, ma se ognuno di voi che legge questo ci supportasse, oggi potremmo espanderci, andare avanti per un altro anno e rimuovere questo fastidioso Banner…
Scommetto 1 Milione di Dollari che il Virus Esiste
Scommetto 1 milione di dollari che il virus esiste. Il processo è breve, il risultato è deciso da un gruppo di scienziati neutrali e tutte le trattative sono tra avvocati. È possibile accettare una qualsiasi delle oltre dodici scommesse.

Riassunto esecutivo
Ho più di una dozzina di argomenti su cui sono pronto a scommettere 1 milione di dollari che ho ragione. Se non siete d’accordo, dovreste accettare la mia scommessa. Potete accettare per un valore compreso tra 200.000 e 1 milione di dollari.
Oppure potete piazzare una scommessa nel pool laterale.
Consultate il foglio dei termini per accettare una delle mie scommesse o per scommettere con o contro di me nel side-pool.
In questo articolo, descriverò la mia scommessa sulla “esistenza o meno del virus” e spiegherò perché scommetto 1 milione di dollari che esiste. Strano, nessuno vuole accettare i miei soldi. Il motivo è semplice: sanno di avere torto. Christine Massey ha detto che sono stati promessi 500.000 dollari. Sono un sacco di soldi per accettare la mia scommessa, dato che ho abbassato il minimo a 200.000 dollari, così non avrebbero avuto scuse per non accettare la mia scommessa.
E quella ricompensa di 1,5 milioni di euro da parte dell’ISOLATE TRUTH FUND? È una truffa. Non c’è modo di contattare le persone che l’hanno offerta per vincolarle a termini legalmente vincolanti. Vedi cosa è successo quando ci ho provato qui sotto.
Le mie scommesse sono tutte reali e sono supportate da accordi definitivi negoziati tra avvocati e da un processo definito nei dettagli. Se pensate che stia bluffando, vi sfido ad accettare.
Introduzione: Esistono i virus?
Esiste un virus? Dai miei sondaggi è emerso che molte persone non sono sicure dell’esistenza di un virus. È una questione importante da risolvere perché i trattamenti che abbiamo presuppongono che esistano!
Purtroppo, nessuno dei principali sostenitori di questa convinzione non vuole più confrontarsi con me o con i miei colleghi sull’esistenza del virus in una discussione aperta e libera per risolvere la questione. Quando il gioco si fa duro, smettono di rispondere.
Ad esempio, Patrick Gunnels ha ammesso che i batteriofagi sono stati isolati (vedi 59:00). Gli ho inviato un’e-mail per fargli notare che i batteriofagi sono virus. Mi ha detto di non contattarlo mai più.
Abbiamo cercato di discutere con tutti loro, ma Christine Massey non ha voluto organizzare il dibattito. Voglio essere perfettamente chiaro. Il nostro team, composto da Kevin McCairn, James Lyons-Weiler, Sin Lee e Richard Fleming, li discuterà in un batter d’occhio. Se Sam Bailey, Mark Bailey, Christine Massey, Tom Cowan, Andrew Kaufman, Alec Zeck e Stefan Lanka vogliono un dibattito, devono accettare in pubblico.
Stiamo facendo un’offerta pubblica per svolgere il lavoro che hanno richiesto, a patto che lo finanzino. Sono loro che non accettano la nostra accettazione della loro offerta.
Dopo che Alec Zeck ha fatto la sua presentazione, quando gli ho chiesto se potevo intervistarlo, ha rifiutato, dicendo che avrebbe sminuito la sfida sul sito web di Sam Bailey. E allora perché ha fatto la presentazione?
Abbiamo anche provato ad accettare la loro sfida sul sito web di Sam Bailey. Kevin McCairn ha accettato. Christine Massey ha fatto ricorso ad attacchi ad hominem contro Kevin e mi ha confessato che non avevano fondi sufficienti per pagare gli esperimenti su cui insistevano. Ha detto che dovrei finanziare io i loro esperimenti. Possiamo parlarne durante il dibattito, in modo che tutti possano capire chi sta dicendo la verità.
Mi sono rimaste poche alternative per ottenere una decisione definitiva e obiettiva su questa importante questione: una scommessa da un milione di dollari utilizzando un processo di accertamento dei fatti giudicato da 3 mediatori professionisti selezionati in modo neutrale e un processo efficiente della durata massima di 6 ore che può essere prolungato su accordo reciproco. Questo è superiore al trascorrere più di due anni in un tribunale tedesco, come ha fatto Lanka con la sua offerta.
In questo modo avremmo un risultato definitivo in poche ore. Se non gradiscono un collegio di tre giudici, possono proporre un’altra alternativa. Sono aperto a qualsiasi modo onesto di emettere un verdetto. Ma nessuna controfferta da parte loro.
Il mio ragionamento era semplice: se ci sono persone che credono veramente che non esista un virus, questo è un modo per raddoppiare molto rapidamente i vostri soldi e dimostrare la tesi.
Se le persone pensano che la mia offerta non sia sincera, dovrebbero accettare. Sono tenuto a pagare loro 25.000 dollari se il mio avvocato non negozia con il loro avvocato in buona fede.
Gli aspetti principali della scommessa sono sotto gli occhi di tutti, quindi non ci sono discussioni su chi ha fatto l’offerta, chi ha accettato, cosa è successo all’udienza e il voto finale dei giudici.
Ho anche suggerito che possono offrire loro stessi la stessa scommessa. Non c’è motivo per cui non dovrebbero farlo, perché per loro è denaro gratis. Se hanno ragione, riceveranno 1 milione di dollari per 6 ore di lavoro in più. Chi non lo farebbe? Possono anche copiare il mio foglio dei termini.
Si rifiutano di accettare la mia scommessa.
Ancora più importante è che si rifiutano di offrire una scommessa comparabile, proprio come ho fatto io.
A differenza dell’ISOLATE TRUTH FUND e della sua sfida, la mia scommessa è semplice, obiettiva, veloce e non richiede esperimenti finanziati da nessuna delle due parti. È facile da accettare. I termini sono chiari. È un processo serio.

Ho proposto loro la scommessa e ho ricevuto solo scuse, come potete vedere dal rifiuto di Christine Massey di accettare il mio milione di dollari: leggete l’intero thread. Il suo rifiuto è sciocco: tutte le trattative contrattuali sono tra avvocati.
Chi pensate stia dicendo la verità? Una parte è ansiosa di ottenere una decisione. L’altra parte sta facendo tutto il possibile per evitare un’udienza equa di fronte a una commissione di tre giudici.
Infine, posso garantirvi che se usassi lo stesso identico termine del contratto ma cambiassi la scommessa in “Scommetto 1 milione di dollari che la gravità non esiste”, sarei sommerso di accettazioni!!! Quindi le persone non accettano questa scommessa perché sanno che perderebbero.
La grande truffa
La scienza consiste nel far coincidere le prove con le ipotesi sul tavolo. L’ipotesi ritenuta più probabile è quella che si adatta meglio a spiegare tutte le osservazioni.
Ma loro vogliono ridefinire il funzionamento della scienza.
Vogliono farvi credere che la prova dell’esistenza di qualcosa dipenda dalla possibilità di isolarla secondo le loro definizioni. Se non si può isolare, non esiste.
Quindi il Bosone di Higgs, che tutti sanno che esiste (ha soddisfatto tutti i test), non può esistere perché nessuno può isolarlo secondo il modo di pensare di Lanka.
Nel 1600 i virus non potevano esistere perché nessuno aveva la tecnologia per isolarli.
La pandemia di influenza del 1918, che potrebbe aver ucciso 100 milioni di persone, non potrebbe essere stata causata dall’influenza perché, secondo Lanka, i virus non esistono.
Fino a 100 milioni di persone sono state uccise da una malattia infettiva e Lanka non ha ipotesi alternative.
Questa è la loro scienza. È stravagante.
Il contesto
Christine Massey, Tom Cowan, Alec Zeck, Patrick Gunnels e altre persone che pensano che i virus non esistano non vogliono impegnarsi in un ulteriore dibattito. Le conversazioni si sono interrotte quando Patrick Gunnels ha ammesso davanti alla telecamera che i batteriofagi sono stati isolati (59:00). Ho fatto notare che i batteriofagi sono virus. Ha detto che non si riproducono perché nessuno li ha visti replicarsi. Gli ho chiesto: “Ok, allora se non si riproducono, chi produce le repliche?”. A quel punto, NON ha risposto e mi ha detto di non inviargli altre e-mail.
Ho chiesto ad Alec Zeck se potevo parlare con lui della sua presentazione. Mi ha risposto di sì e mi ha chiesto se poteva portare con sé i co-creatori.
Ho risposto “Certo!!!”
Mi ha poi risposto che, poiché c’era già una sfida da parte di Sam Bailey, voleva aspettare che ci fosse un risultato.
Ma sa che non hanno accettato l’offerta di Kevin di fare tutto il lavoro di ricerca che volevano e che lui avrebbe filmato ogni passo in modo che potessero vedere che è a livello senza trucchi. La sua offerta è stata ignorata.
Quindi la loro sfida è fraudolenta e usano la mancanza di risposta alla loro sfida per ignorare la mia sfida.
Alec ha commentato il mio articolo e poi, quando gli ho chiesto di accettare la mia offerta, è rimasto in silenzio, come potete vedere:

La scommessa
Avevo bisogno di un modo per smascherare pubblicamente la loro ipocrisia senza coinvolgerli in un dibattito, visto che non si presenteranno.
Così ho ideato una scommessa da 1 milione di dollari per dimostrare pubblicamente che non sono onesti e che sono loro a tirarsi indietro.
Ci sono due vecchi detti:
Uno sciocco e il suo denaro si separano presto
Metti i tuoi soldi al posto della bocca
Piuttosto che una serie infinita di dibattiti in cui il pubblico è diviso su chi sia il “vincitore” o su cosa significhi “scienza”, andiamo dritti al punto.
Se credete a una delle due cose:
Il virus SARS-CoV-2 non esiste
Che i virus in generale non esistano o una qualsiasi altra dozzina di “credenze” elencate nei termini del contratto
allora vi sfido a scommettere 1 milione di dollari.
Usiamo le definizioni comunemente accettate di virus e di “esistenza”. Se non le piace, scelga il suo dizionario preferito e lo negozieremo. È tutto nel regolamento.
Inoltre, chi perde (per perdere è necessario che tutti e tre i giudici votino contro di voi) deve accettare di scusarsi pubblicamente e ammettere di aver sbagliato.
Se siete sicuri di aver fatto bene, dovreste cogliere al volo l’opportunità di raddoppiare i vostri soldi. Basta creare una LLC con un gruppo di amici. Vale la pena di pagare il costo della LLP.
L’ISOLATE TRUTH FUND ha più che sufficienti fondi a disposizione per accettare la mia sfida. Si tratta di un’operazione che può essere vinta ed è un ottimo modo per raddoppiare rapidamente i loro soldi.
Sono disposto a superare il milione di dollari se riuscite a raccogliere più fondi.
Se avete bisogno di modifiche, includetele nella vostra accettazione.
Potete vedere chi ha accettato questa scommessa finora qui. Queste sono le persone che credono veramente che il virus non esista.
Non vedo l’ora di sentirvi.
Sarà bello vedere chi dice la verità. Chi dice la verità ha un grande incentivo ad accettare la mia offerta.
L’ ISOLATE TRUTH FUND ha più di 1 milione di dollari a disposizione, quindi le persone che pensano che questo importo sia troppo alto per essere ragionevole si sbagliano. I soldi sono disponibili. La volontà di far decidere la verità da un collegio imparziale di tre giudici statali/federali in pensione non lo è.
Accettare la mia scommessa
Puoi vedere chi ha accettato questa scommessa finora qui.
ATTENZIONE Non fare giochetti. La mia offerta di 1 milione di dollari è assolutamente seria.
Se compilate il modulo, state stipulando un accordo legale per accettare la mia offerta e procedere alla negoziazione di eventuali modifiche ai termini del contratto e all’accordo definitivo.
Sono previste significative sanzioni pecuniarie in caso di inadempimento da parte di una delle due parti.
Se state facendo un’accettazione condizionata perché non siete soddisfatti di uno o più termini nel foglio, specificate le condizioni nella vostra accettazione.
Gli attacchi ad hominem
Gli antivirali, come Christine Massey, sostengono che sono una persona cattiva e quindi non scommettono su di me. Ma la scienza non si basa su attacchi ad hominem. Dovrebbe basarsi su persone che vogliono trovare la verità. Provo per lei le stesse cose che lei prova per me, ma sono disposto a mettere da parte tutto questo per poter risolvere questa importante questione. Lei non è in grado di farlo.
Mettiamola in un altro modo:
Nulla impedisce loro di offrire la stessa sfida e le stesse condizioni a tutti gli interessati. Dovrebbero cogliere al volo l’opportunità di guadagnare milioni di dollari da persone come me.
Che grande raccolta di fondi per loro (e hanno bisogno di fondi perché Christine ha ammesso di non avere fondi per pagare la sfida che hanno offerto e nessuno farà il lavoro gratuitamente).

Ma non offriranno la stessa scommessa che ho fatto io perché sanno che perderebbero in un test equo davanti a 3 giudici selezionati a caso.
Non hanno assolutamente alcuna scusa per non offrire la stessa scommessa che ho offerto io utilizzando lo stesso (o simile) foglio di istruzioni. Lanka ha offerto 100.000 euro a chiunque fosse in grado di dimostrare che si sbagliava e non ha avuto alcun vantaggio da questa offerta. Lo vedete fare lo stesso con la SARS-CoV-2? Certo che no. Lanka sa che perderebbe alla prova dei fatti, proprio come è successo in Germania. Ecco perché non ripete la sua offerta con la SARS-CoV-2. Naturalmente, aveva una “via d’uscita” perché richiedeva che il vincitore fornisse la prova in un’UNICA pubblicazione e Bardens ha fornito sei documenti per dimostrare l’esistenza del morbillo.
Il tribunale tedesco ha sostanzialmente affermato che Bardens ha dimostrato l’esistenza del virus del morbillo, ma che ciò è avvenuto in più di un articolo.
Un solo documento? Ma siete seri? La scienza non funziona così. Nessuno scienziato legittimo avrebbe una tale restrizione su una prova di un argomento così importante. L’articolo di wikipedia commenta persino quanto sia ridicola questa restrizione:
Sono state presentate sei pubblicazioni che hanno dimostrato collettivamente l’esistenza del virus del morbillo e del suo diametro; tuttavia non sono riuscite a soddisfare i requisiti del concorso stabiliti da Lanka, che aveva stabilito che entrambi i dettagli dovessero essere trattati in un’unica pubblicazione, cosa che sarebbe stata improbabile visto l’obiettivo ristretto delle singole pubblicazioni.
Lanka ha perso in tribunale sui fatti (i tribunali superiori si pronunciano solo sui punti di diritto). Eppure, ancora oggi, Lanka proclama che i virus non esistono.
Quindi, facciamo questa cosa in modo più efficiente davanti a 3 giudici, in modo che il mondo intero possa vedere quanto sia sbilanciata la determinazione. Perdere 3 giudici su 3 dovrebbe mostrare al mondo chi dice la verità.
E facciamolo con soldi seri. Hanno bisogno di questo tipo di denaro per finanziare la scienza alla base della loro sfida. Quindi questa scommessa risolverà il loro problema di finanziamento.
Il fatto che non vogliano farlo dimostra che non credono davvero in quello che dicono.
In Texas c’è un termine per questo:

Christine, se non ti piace la mia offerta, vediamo la TUA scommessa a tutti i concorrenti con condizioni simili alle mie.
L’offerta del Fondo isolato per la verità
C’è un sito tedesco che sostiene di essere l’ISOLATE TRUTH FUND.
La loro sfida è stupida.
Abbiamo 100 anni di osservazioni tutte coerenti con la virologia e nessun mistero. Perché non elencano semplicemente le osservazioni esistenti non spiegate che inducono le persone a mettere in dubbio la virologia? Il fatto che nessuna delle loro spiegazioni sia in grado di spiegare il sito di clivaggio della furina rende dubbia ogni singola ipotesi alternativa. Se pensate che la virologia non spieghi l’evidenza, dovete offrire un’ipotesi migliore.
Nella pagina dell’offerta non c’è modo di accettare/rispondere o visualizzare il loro documento dei termini!
Voglio conoscere le persone che stanno dietro l’offerta. Voglio poter parlare con loro per chiarire come verranno decise le cose. Voglio un contratto scritto e vincolante. Voglio un pagamento anticipato che copra le spese effettive per il lavoro di laboratorio richiesto.


Quando ho premuto Invia, ho ottenuto questo:
Se vi state chiedendo perché non ho accettato l’offerta, ecco perché. L’hanno giocata in modo che non ci siano persone associate e non c’è modo di accettare la loro offerta.
Non c’è modo di accettare che io abbia trovato. E gli esperimenti che richiedono costano. Sono disposti a finanziarli?
Qual è il processo decisionale? Chi decide? Possono giocare con il processo decisionale e lasciarmi in perdita?
Allora, perché la gente mi ha indirizzato a questa sfida? È questo il modello?
Perché nessuno mi dice come contattare queste persone e parlare con loro?
La mia offerta è molto più semplice, il processo decisionale è completamente specificato, c’è un luogo di accettazione che funziona, le persone che accettano sono sotto gli occhi di tutti, si può fare in 6 ore e non richiede alcun tipo di lavoro di laboratorio.
Questo sito web mostra che c’è denaro più che sufficiente a disposizione di chiunque di loro per accettare la mia scommessa. Quindi Sam Bailey e altri possono semplicemente chiedere al fondo per la verità sull’isolamento di finanziare la loro scommessa e raddoppiare i loro soldi, io sarò felice di aumentare la scommessa a 1,5 milioni di euro in un batter d’occhio!
O perché ISOLATE TRUTH FUND non accetta la mia scommessa? La mia scommessa è un modo più veloce per raddoppiare i loro soldi senza rischi (se si è sicuri che non ci siano rischi).
Vorrei avere i loro dati di contatto.
Patrick Gunnels, che diceva che i virus non esistono, ha ammesso che esistono.
Guardate questo video a 59:00.
Gunnels, che è un esperto di questa materia (ha studiato virologia a Lanka), ha detto che i batteriofagi esistono e sono stati isolati usando un’ultracentrifuga. Ha citato questo fatto come prova che è possibile isolare piccole particelle.
C’è un problema. I batteriofagi sono virus.
Da uno dei miei seguaci che ha una formazione in batteriologia:
Quando l’ho fatto notare a Gunnels, mi ha detto di non contattarlo più.
È così che funziona l’indagine scientifica, credo.
La scusa addotta da Christine Massey per non aver accettato la scommessa
Le sue scuse per non accettare il mio milione di dollari sono le seguenti:
Non le piaccio e non si fida di me
Dice che questo distrarrebbe dalla loro sfida
Non è sicura di come verrebbe decisa la scommessa.
La mia risposta a ciascun punto:
Neanche a me piace o mi fido di Christine. Ma è importante scoprire chi dice la verità. Sono disposto a ignorare i sentimenti personali perché (a) voglio risolvere la questione e (b) l’accordo è applicabile in tribunale ed entrambe le parti sanno cosa contiene. Non è necessaria la fiducia dell’altra parte. Tutte le negoziazioni degli accordi avvengono tra avvocati. Kevin McCairn ha accettato la sua sfida e loro si sono rifiutati di finanziarlo per portare a termine gli esperimenti che volevano. Hanno ammesso di non avere i fondi necessari.
Quindi la loro sfida è insincera. A quanto pare, forniranno ogni sorta di scusa per non accettare l’accettazione da parte di chiunque voglia svolgere il lavoro. Non c’è motivo per cui non possano fare entrambe le cose. La mia scommessa può essere risolta rapidamente senza alcun esperimento di laboratorio. La mia scommessa fornirebbe i finanziamenti che non hanno (ma di cui hanno bisogno) per la loro sfida.
Mi limiterò a utilizzare le prove raccolte in oltre 100 anni di esistenza della virologia. Perché queste prove non sono sufficienti per decidere quale ipotesi si adatta alle osservazioni degli ultimi 100 anni? Inoltre, la mia scommessa ha un modo per risolvere le controversie in modo equo. La loro no. Possono sostenere che Kevin ha mentito. Inoltre, la loro sfida è irrilevante: “È nell’interesse di tutti affrontare la questione dell’isolamento”. L’isolamento è una distrazione.
L’isolamento non è necessario per dimostrare l’esistenza di un virus. Inoltre, i batteriofagi sono stati isolati e sono virus. Gunnels lo ha ammesso al minuto 59:00. Guardate. Quindi la loro sfida è sciocca. Christine usa la scusa di non aver letto le condizioni della scommessa per non accettarla. Ma davvero? Tutte le regole sono lì. Se non le piace qualcuna, il loro avvocato può negoziare con il nostro avvocato eventuali modifiche.
È una perdita di tempo?
No. Ci sono molte persone che si lasciano ingannare dall’assurdità del “per dimostrare che qualcosa esiste, bisogna isolarlo in base alle mie specifiche”.
È importante risolvere questo problema. La scommessa fa queste cose:
Smaschera queste persone come diffusori di disinformazione.
Ci permette di concentrarci sulla questione principale: il vaccino e il virus.
Mostra come un gran numero di persone possa essere facilmente manipolato da presunti esperti.
Chiude definitivamente la questione Fornisce 1 milione di dollari in più che possono essere spesi dalla VSRF per il nostro lavoro.
Dimostra che non vogliono risolvere la questione in modo rapido, oggettivo e con una sanzione per chi si sbaglia.
Se accettano, perderanno la scommessa.
Se non accettano, è una tacita ammissione che non credono di avere un argomento convincente. I giudici ascolteranno gli esperti di entrambe le parti. Di cosa hanno paura? Risolviamo la questione. Non lo faranno perché sanno che perderanno.
Sintesi
Ho strutturato questo discorso in modo che gli antivirus non abbiano più scuse per non accettare la mia scommessa. Per loro sono soldi gratis.
La scusa che la scommessa è troppo grande è solo una scusa. L’ISOLATE TRUTH FUND ha più che abbastanza denaro a disposizione per accettare qualsiasi mia scommessa. Christine Massey ha ammesso che hanno 500.000 dollari di donazioni, più che sufficienti per soddisfare la scommessa minima di 200.000 dollari.
Se non gradiscono la mia offerta, dovrebbero fare la loro offerta con una struttura identica (invece di inventare una sfida che nessuno può vincere come ha fatto Lanka). Se offrono le stesse condizioni, accetterò la loro scommessa.
Ma non accetteranno la mia scommessa né proporranno la loro. Offriranno solo scuse e altre scuse.
Se qualcuno ha un modo migliore per risolvere la questione in modo più rapido e oggettivo alla luce dei vincoli attuali, sono tutto orecchi.
Ma per favore, gente, non discutiamo i meriti nei commenti. È a questo che serve la scommessa.
Steve Kirsch’s
Fonte: stevekirsch.substack.com

SOSTIENICI TRAMITE BONIFICO:
IBAN: IT19B0306967684510332613282
INTESTATO A: Marco Stella (Toba60)
SWIFT: BCITITMM
CAUSALE: DONAZIONE




